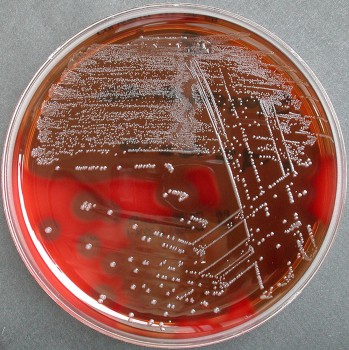
Kolonies van GAS met hemolyse

De kern
Groep A-streptokokken (GAS) vulvovaginitis is een nog weinig onderkende gynaecologische aandoening bij volwassen vrouwen.
Overweeg een banale kweek om minder vaak voorkomende verwekkers van vulvovaginale klachten, zoals GAS, op te sporen wanneer de vaginale en/of mictieklachten aanhouden, UWI en soa zijn uitgesloten, en de initieel ingezette diagnostiek en behandeling volgens de NHG-Standaard Fluor vaginalis heeft gefaald.
Als de vaginale kweek een GAS toont, is deze uitstekend te behandelen met penicilline 4 dd 500 mg per os gedurende tien tot veertien dagen.
In de eerste maanden van 2017 is in Nederland een verergering gerapporteerd van het aantal invasieve Streptococcus pyogenes-infecties. Invasief wil zeggen dat de infectie doordringt in onderliggende weefsels en de bloedbaan. Van januari tot en met april 2017 zijn in Nederland 158 gevallen van invasieve Streptococcus pyogenes-infecties gemeld, terwijl dat er in de voorgaande vijf jaren in dezelfde periode gemiddeld 88 waren.1
Streptococcus pyogenes, ook wel groep A-streptokok (GAS) genoemd, hangt ook samen met milder verlopende, niet-invasieve infecties, zoals keelontsteking of oppervlakkige huidinfecties. Minder bekend is dat GAS ook vulvovaginitis of perianale infectie bij kinderen en volwassen kan veroorzaken.
Van januari tot en met april 2017 zijn 3728 genitaalkweken naar het diagnostisch centrum Saltro gestuurd, waarvan bij 3% (111 monsters: 109 vrouwen en 2 mannen) GAS werd geïsoleerd. GAS vinden we vooral bij meisjes in de leeftijdsgroep van 0 tot 10 jaar en minder vaak bij vrouwen in de leeftijdsgroep 30 tot 40, 50 tot 60 en 60 tot 70 jaar.2 GAS vulvovaginitis is een onderkende gynaecologische aandoening bij prepuberale meisjes, bij volwassen vrouwen is het een relatief onbekend ziektebeeld. In een patiëntcontroleonderzoek vond men GAS bij 4,9% (49/1010) van de volwassen vrouwen met vulvovaginitis. In de controlegroep zonder klachten was geen sprake van GAS.3
CASUS
Mevrouw Z, 49 jaar oud, heeft klachten over vaker plassen en de urine moeilijk ophouden. De urinestick toont nitriet-, leuko1+, ery-. De displide is negatief. De klachten persisteren en u verricht een uitgebreide anamnese en (gynaecologisch) onderzoek. Mevrouw Z denkt dat de urine die ze verliest bij nader inzien waarschijnlijk afscheiding is; gelig en dun met een onfrisse geur. Haar schaamlippen en vagina voelen geïrriteerd aan. Een soa kunt u anamnestisch met zekerheid uitsluiten. Bij speculumonderzoek valt een forse aanspanning van de bekkenbodemspieren op, de vaginawanden zijn rood en er is veel witgele fluor. Aanvullend onderzoek toont een pH van 4,1 (normaal) en een negatieve aminetest. De gistkweek die u hebt afgenomen is negatief.
Omdat de klachten en de afwijkingen bij lichamelijk onderzoek aanhouden neemt u twee weken later een banale kweek af, omdat u vermoedt dat er sprake is van een vaginitis met nog onduidelijke focus. Hiermee wijkt u af van de adviezen uit de NHG-Standaard Fluor vaginalis. De kweek laat een vulvovaginitis op basis van Streptococcus pyogenes zien. Het diagnostisch onderzoek naar bacteriële vaginose, candida en trichomonas is negatief.
Ziektebeeld
GAS vulvovaginitis bij volwassen vrouwen gaat gepaard met klachten over vulvaire pijn/branderigheid/jeuk, dyspareunie en/of fluor. Soms zien we slechts klassieke klachten van een urineweginfectie, zoals in onze casus, waarbij vrouwen vaak een branderig gevoel bij het plassen hebben. Ook bij mannen kan GAS samenhangen met genitale klachten; zo was er onlangs een casus waarbij de echtgenoot van een vrouwelijke patiënt met GAS rode, pustuleuze laesies op de glans penis had.
GAS vulvovaginitis bij volwassen vrouwen vinden we vaker wanneer een of meer van de volgende factoren aanwezig zijn: huid- of luchtweginfectie met GAS in de voorgeschiedenis (persoonlijk of van huisgenoten), seksueel contact en lactatiegerelateerde of menopauzale vaginale atrofie.4
Een zeldzame complicatie van GAS vulvovaginitis is het streptokokken toxic shock syndrome. Er is een casus uit 2015 van twee postmenopauzale patiënten die buikpijn, koorts, hypotensie en multiorgaanfalen (toxic shock syndrome) hadden. Een bloedkweek en/of vaginale kweek was positief voor GAS, zonder aanwijzingen voor een andere relevante focus dan een GAS vaginitis.5
Diagnostiek
GAS zijn grampositieve kokken die in ketens liggen [figuur1]. Ze behoren tot de hemolytische streptokokken, omdat rondom de bacteriekolonies hemolyse zichtbaar is op een zogenaamde bloedagarplaat [figuur2]. GAS vulvovaginitis is te diagnosticeren met een banale bacteriële kweek.
Figuur 2 Kolonies van GAS met hemolyse op een bloedplaat
Het stappenplan voor aanvullend onderzoek van de NHG-Standaard Fluor vaginalis noemt deze vorm van diagnostiek niet. Wanneer u een UWI en soa hebt uitgesloten, adviseren wij echter om wél een bacteriële kweek te verrichten, zeker bij een atypische uiting en aanhouden van de klachten bij afwijkend vulvovaginaal onderzoek, en als initiële diagnostiek en/of behandeling volgens de NHG-Standaard Fluor vaginalis geen aanvullende aanknopingspunten oplevert en/of faalt. Zo kunt u minder vaak voorkomende, maar behandelbare verwekkers van vulvovaginale klachten opsporen, zoals GAS, maar ook S. aureus, S. pneumoniae en H. influenzae.
Behandelopties
Er zijn geen richtlijnen over of trials verricht naar de behandeling van GAS vulvovaginitis. Op basis van casusonderzoek heeft men behandelopties voor GAS vulvovaginitis opgesteld: penicilline 4 dd 500 mg oraal gedurende 10 tot 14 dagen of clindamycine 2% vaginale crème gedurende 7 tot 10 dagen.6 Zoals verwacht waren alle GAS die wij in kweken vonden gevoelig voor penicilline. Erytromycine- en clindamycineresistentie treden vaak samen op en vonden we bij 6% van de GAS. Als onderdeel van de behandeling kunt u bij patiënten met een risico op lactatiegerelateerde of menopauzale vaginale atrofie ook aanvullend vaginale oestrogeencrème of -ovules gebruiken.4
Recidief
Over het recidiefpercentage van GAS vulvovaginitis is weinig bekend. Overdracht naar het genitaal gebied kan genitaal, oraal of via de huid (hand) plaatsvinden. Aangezien we GAS-dragerschap in de farynx, gastro-intestinaal/anaal en genitaal vinden, is het raadzaam bij recidiverende GAS vulvovaginitis dragerschap van de genoemde plekken van de partner en eventuele andere huisgenoten te onderzoeken en te behandelen.4
Vervolg casus
Het bij de uitslag van de kweek geleverde antibiogram voorspelt sensitiviteit voor onder andere penicilline. In overleg met de microbioloog start mevrouw met feniticilline 4 dd 500 mg oraal, gedurende tien dagen. Twee dagen na de start van de behandeling heeft mevrouw Z al aanzienlijk minder klachten en na vijf dagen is ze volledig klachtenvrij. Tot op heden is er geen sprake van een recidief.
Literatuur
- 1.↲RIVM. Osiris-Algemene Infectieziekten (AIZ), RIVM signaleringsoverleg. Bilthoven: RIVM, 2017.
- 2.↲Ranđelović G, Mladenović V, Ristić L, Otašević S, Branković S, Mladenović-Antić S, et al. Microbiological aspects of vulvovaginitis in prepubertal girls. Eur J Pediatr 2012;171:1203-8.
- 3.↲Bruins MJ, Damoiseaux RAMJ, Ruijs GJHM. Association between group A beta-haemolytic streptococci and vulvovaginitis in adult women: a case-control study. Eur J Clin Microbiol Infect Dis 2009;28:1019-21.
- 4.↲↲↲Verstraelen H, Verhelst R, Vaneechoutte M , Temmerman M. Group A streptococcal vaginitis: an unrecognized cause of vaginal symptoms in adult women. Arch Gynecol Obstet 2011;284:95-8.
- 5.↲Hikone M, Kobayashi K, Washino T, Ota M, Sakamoto N, Iwabuchi S, et al. Streptococcal toxic shock syndrome -secondary to group A Streptococcus vaginitis. J Infect Chemother 2015;21:873-6.
- 6.↲Sobel JD. Approach to women with symptoms of vaginitis. Beschikbaar via . https://www.update.com/contents/approach-to--women-with-symptoms-of-viginitis
Reacties
Er zijn nog geen reacties.